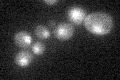
YLR451W
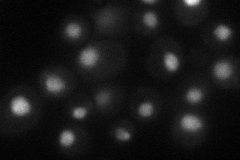
YLR451W
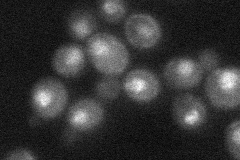
YLR451W

View description
Zinc-finger transcription factor that regulates genes involved in branched chain amino acid biosynthesis and ammonia assimilation; positively regulated by alpha-isopropylmalate, an intermediate in leucine biosynthesis
Localization:
Intensity:
Fold change:
Significance:
-
C’ GFP library in SD
nucleus20.75 -
N' NOP1pr-GFP in SD
nucleus40.1128 -
N' TEF2pr-mCherry in SD

nucleus45.4328 -
N' NATIVEpr-GFP in SD
punctate,nucleus27.6369 -
N' TEF2pr-VC and Cyto-VN in SD

#N/A0 -
C’ GFP library in SD+DTT

nucleus22.341.07No -
C’ GFP library in SD+H2O2

nucleus18.420.88No -
C’ GFP library in Starvation Media

nucleus17.340.83Yes -
C’ GFP library on the background of Pup2-DaMP

nucleus -
C’ GFP library on the background of CCT mutant

nucleus24.21031.16664No
